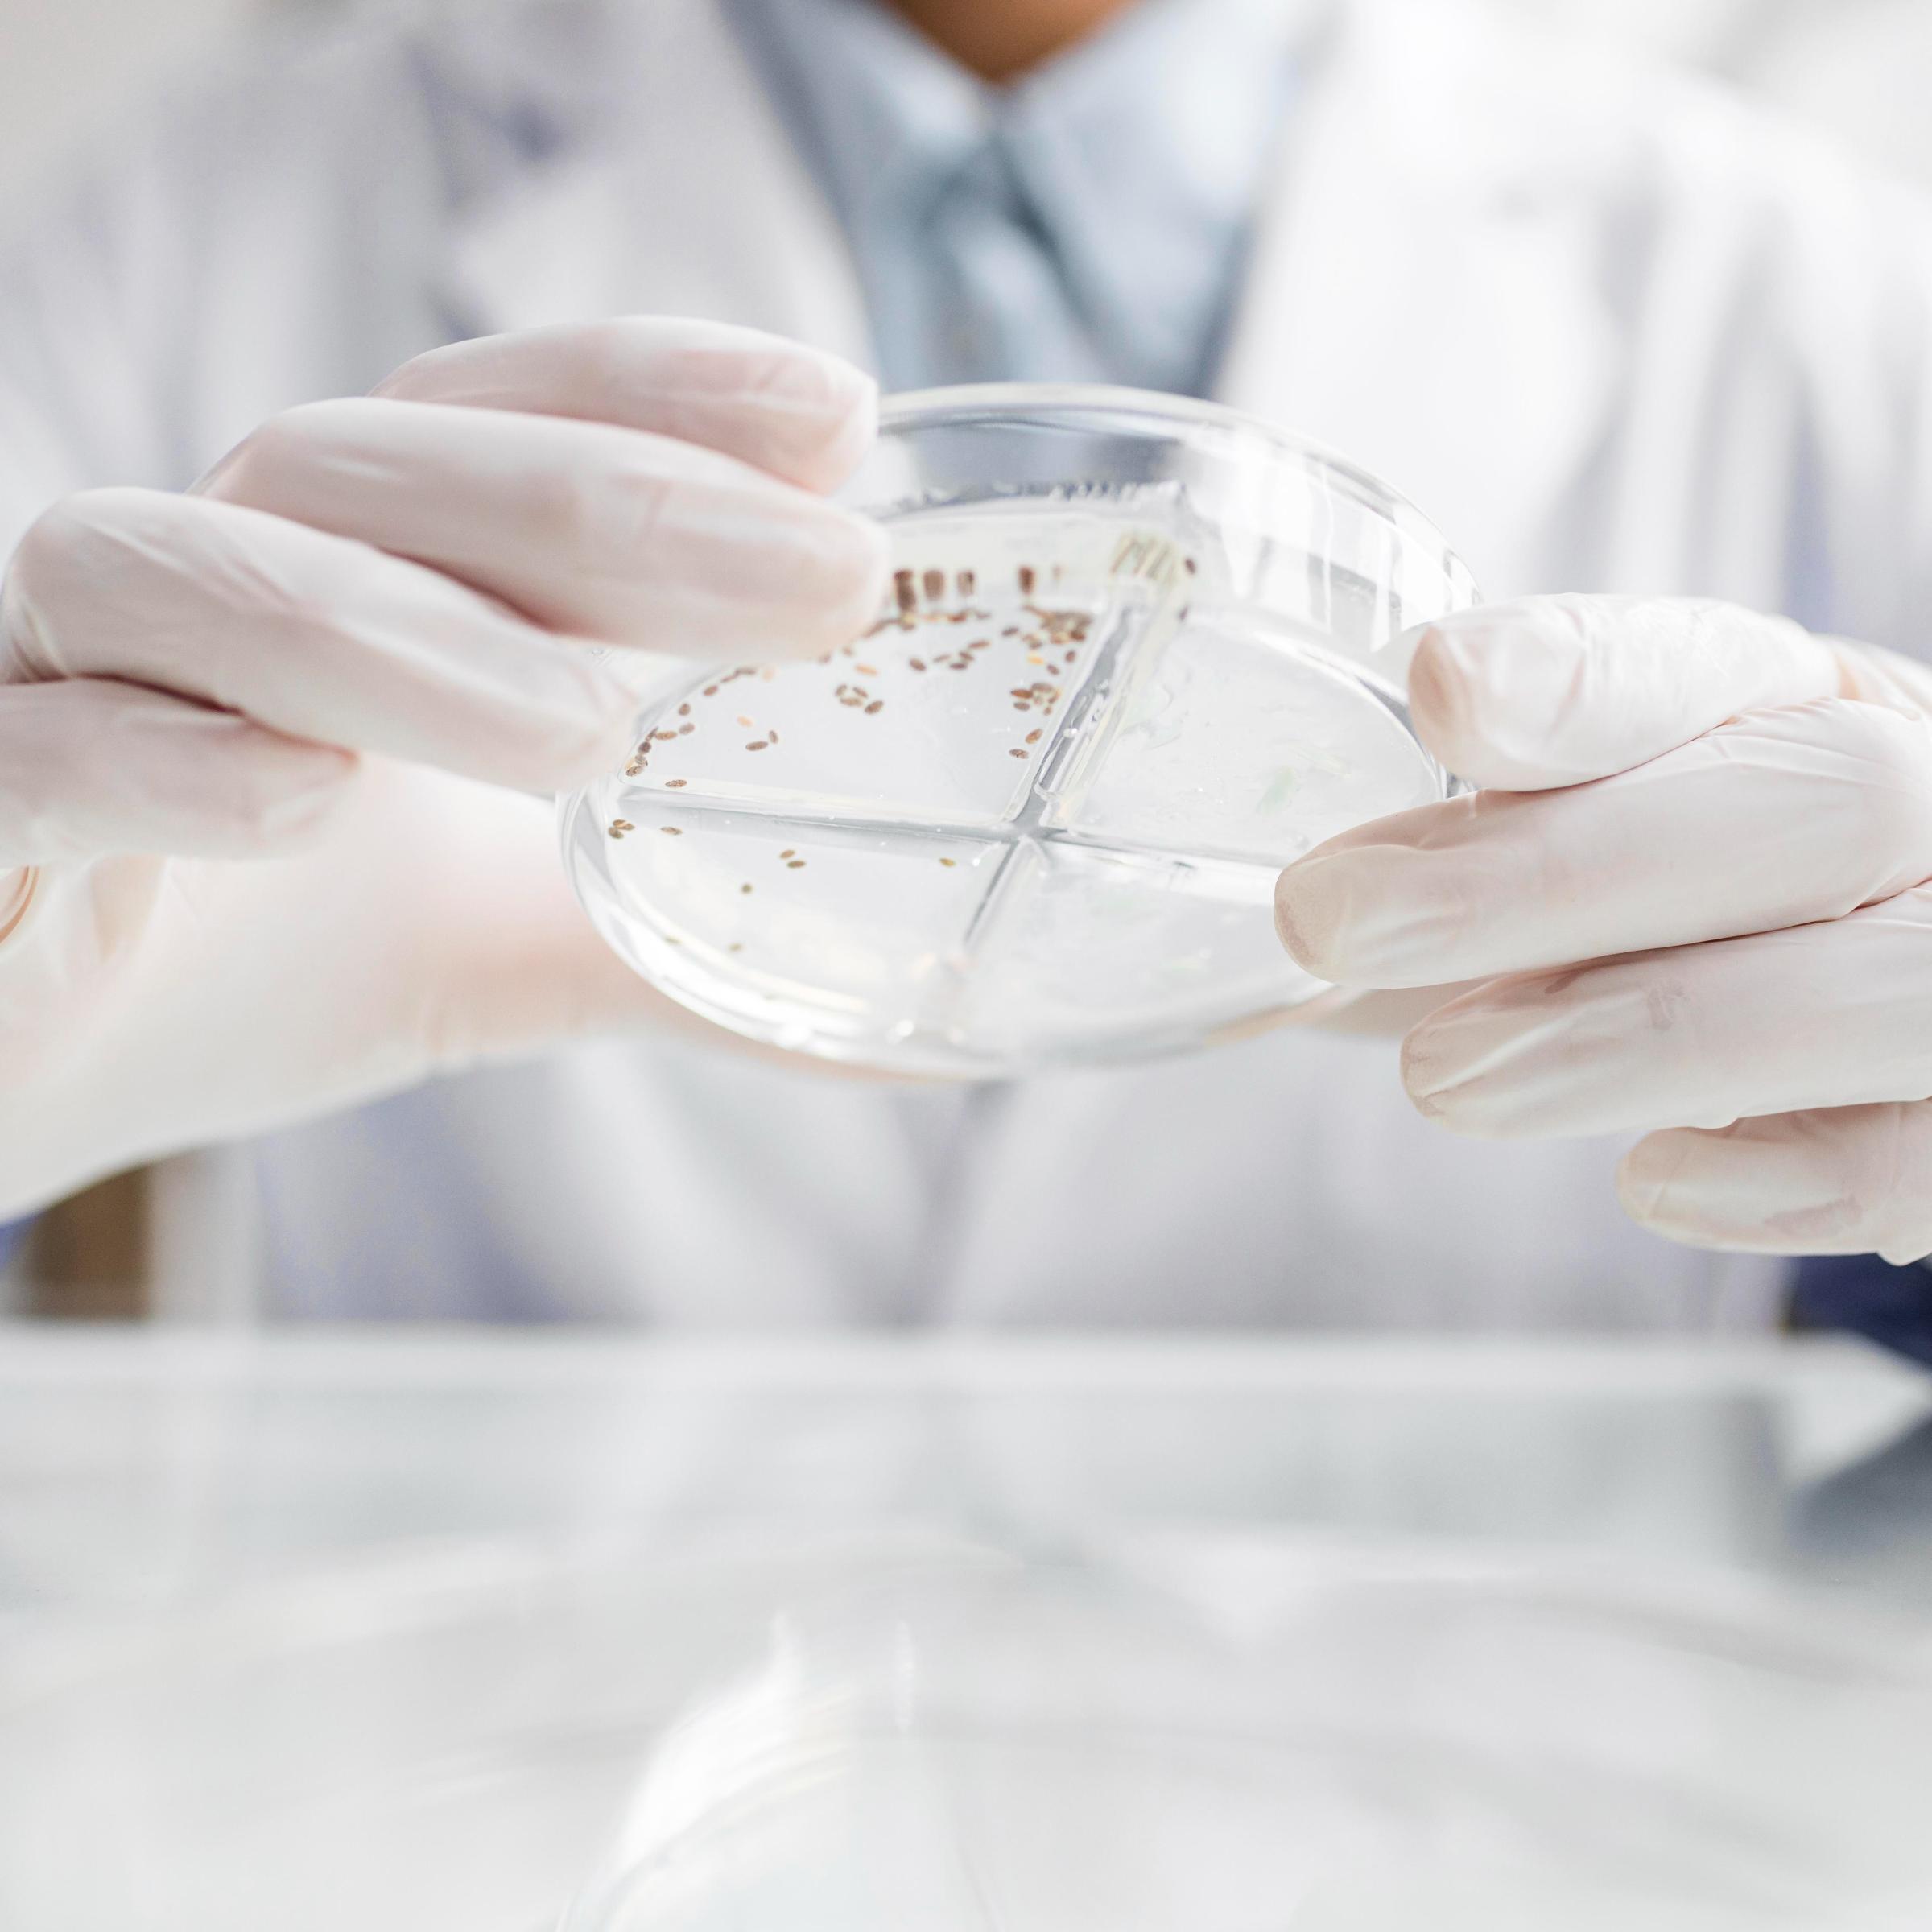

We are dedicated to microbial sciences
Our understanding of the gut microbiome and its role in human health continues to evolve rapidly – and the full health potential of many probiotic strains and microbiome modulation is yet to be fully realized.
An increasing amount of advanced scientific studies are highlighting the pivotal role that the microbiome – now considered an organ in its own right – plays in human health and wellbeing.